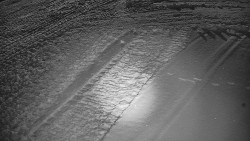
Otočná kamera na sjezdovce

Deštné v Orlických horách
Pohled na sjezdovku Marta I. a na lanovku na Studený vrch.
Obec Letonice
Pohled na obec Letonice od jihovýchodu směrem na Rousínov.
Zdroj: www.eleco.cz
Ski areál SEVERKA v Dolní Lomné
Pohled na sjezdovku 1 a 3 ve skiareálu Severka v Dolní Lomné
Skiareál Karolinka
Kamera snímá sjezdovku, horní část
Lyžařský vlek Karlova Studánka
Pohled na sjezdovku v lyžařském areálu Pradědova aréna.
Ski areál SEVERKA v Dolní Lomné
Pohled na bazén
Skiareál Troják
Kamera ukazuje parkoviště z kopce Maruška nad lyžařským střediskem Troják.
SkiAreál - Horský hotel Vsacký Cáb
Sdružený snímek z kamer na Vsackého Cábu ve Vsetínských Beskydech
Ski areál SEVERKA v Dolní Lomné
Chata Severka - sdružený snímek
Město Bruntál
Pohled na náměstí Míru v Bruntále.
Zdroj: mx-net.cz
Město Most
Centrum města Most, vlevo hrad Hněvín, v pozadí Krušné hory.
Město Liberec
Pohled z Dolního Hanychova přes Liberec na Jizerské hory.
Zdroj: www.anetliberec.cz
Skiareál Bílá
Pohled z horní části lyžařského svahu skiareálu Bílá, vlevo Smrk, vpravo Lysá hora.
CHKO Pálava
Pohled na místo určené pro kiteboarding na novomlýnských nádržích.
Město Brno
Pohled na Špilberk a katadrálu sv. Petra a Pavla.